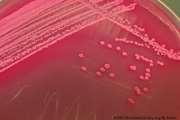

سایت دانشگاه |
04 آذر 1404

مرکز تحقیقات مقاومت میکروبی و مدیریت مصرف آنتی بیوتیک ها
دانشگاه علوم پزشکی تهران
مطالب اخیر
- 1404/09/04 میکروبهای مقاوم، قاتلان جدید در بیمارستانها
- 1404/09/04 هشدار جدی متخصصان درباره بحران مقاومت میکروبی بعنوان عامل ۲۰ درصد از مرگومیر در بیمارستان ها
- 1404/09/04 دکتر آرش سیفی: مقاومت میکروبی یک تهدید جدی برای سلامت امروز و آینده کشور است
- 1404/09/04 تاکید معاون درمان دانشگاه علوم پزشکی تهران بر مصرف بهینه آنتیبیوتیک ها و کاهش مرگ و میر ناشی از مقاومت میکروبی
- 1404/08/28 برگزیدگان دومین جشنواره هنری دانشجویی مقاومت میکروبی معرفی شدند
- 1404/08/28 سومین کنفرانس علمی مصرف بهینه آنتیبیوتیکها برگزار شد
- 1404/08/27 نمایشگاه آثار دومین جشنواره هنری دانشجویی مقاومت میکروبی و مدیریت مصرف آنتیبیوتیکها دایر شد